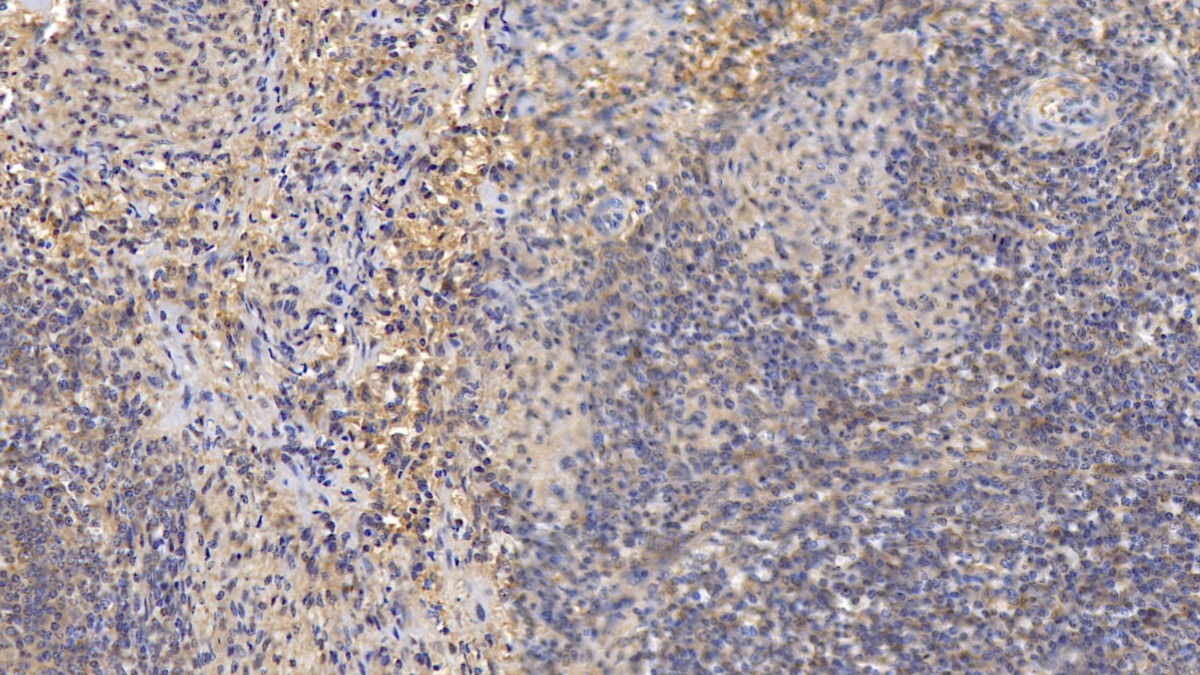
https://d1vffmuvmgkypt.cloudfront.net/image/ridacom_ltd/cloud_clone_corp/PRODUCT_SOURCE__CLOUD_CLONE__SUPPLIER__RIDACOM__ID__MAA103Hu22__1
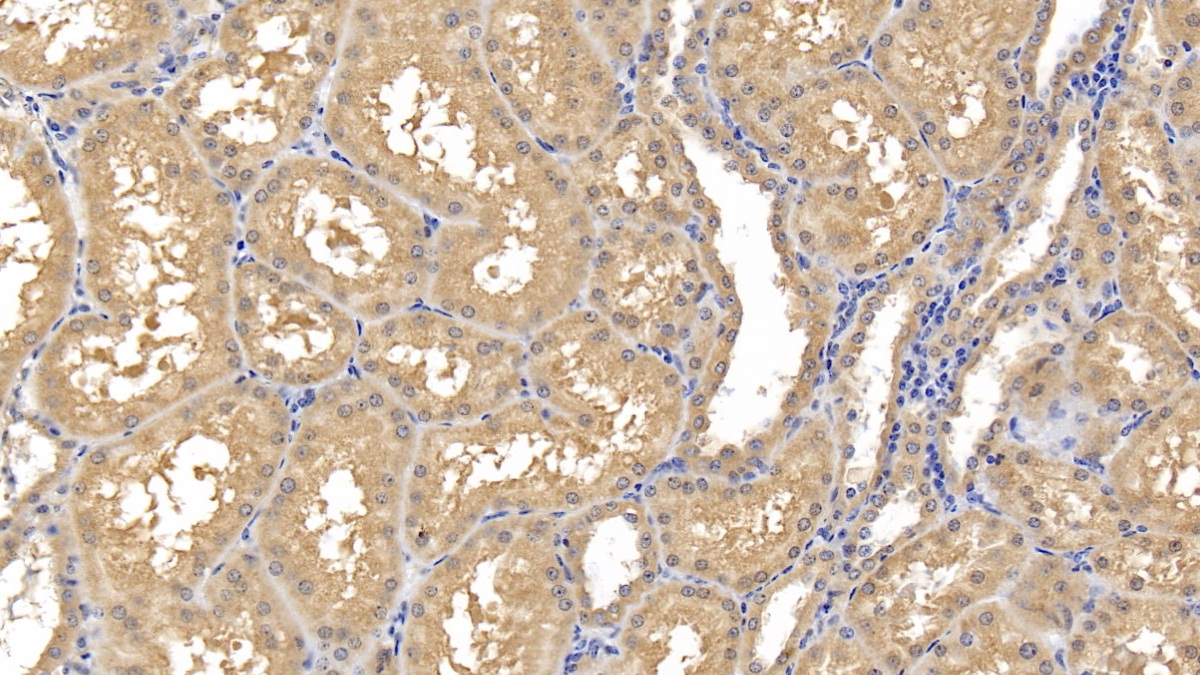
https://d1vffmuvmgkypt.cloudfront.net/image/ridacom_ltd/cloud_clone_corp/PRODUCT_SOURCE__CLOUD_CLONE__SUPPLIER__RIDACOM__ID__MAA103Hu22__2

Antigen
CLG2
Reactivity
Human
(7)
Rat
(4)
Mouse
(3)
Guinea Pig
(1)
Research area
Cardiovascular biology
(8)
Enzyme & Kinase
(8)
Infection immunity
(8)
Clonality
Polyclonal
(3)
Monoclonal
(1)
Application
Western Blotting
(8)
Immunocytochemistry
(6)
Immunohistochemistry
(6)
Enzyme-linked immunosorbent assay for Antigen Detection
(4)
Immunoprecipitation
(4)
Chemiluminescent immunoassay for antigen detection
(3)
Positive Control
(2)
SDS-PAGE
(2)
Immunofluorescence
(1)
Host
Rabbit
(3)
293F
(1)
CHO
(1)
Mouse
(1)
Category
ELISA Kits
(7)
Antibodies
(6)
Cell biology
(2)
Immunochemicals
(2)
Protein Biochemistry
(2)
| 48T | $638.00 | |
| 96T | $912.00 | |
| 96T*5 | $4,104.00 |
| 96T*10 | $7,752.00 | |
| 96T*100 | $63,840.00 |
| 48T | $605.00 | |
| 96T | $864.00 | |
| 96T*5 | $3,888.00 |
| 96T*10 | $7,344.00 | |
| 96T*100 | $60,480.00 |
| 48T | $588.00 | |
| 96T | $840.00 | |
| 96T*5 | $3,780.00 |
| 96T*10 | $7,140.00 | |
| 96T*100 | $58,800.00 |
| 48T | $504.00 | |
| 96T | $720.00 | |
| 96T*5 | $3,240.00 |
| 96T*10 | $6,120.00 | |
| 96T*100 | $50,400.00 |
| 48T | $479.00 | |
| 96T | $684.00 | |
| 96T*5 | $3,078.00 |
| 96T*10 | $5,814.00 | |
| 96T*100 | $47,880.00 |
| 48T | $454.00 | |
| 96T | $648.00 | |
| 96T*5 | $2,916.00 |
| 96T*10 | $5,508.00 | |
| 96T*100 | $45,360.00 |

Antigen:
Matrix Metalloproteinase 8
Synonyms: CLG2; HNC; PMNL-CL; Collagenase 2; Neutrophil Collagenase; PMNL collagenase
Reactivity:Human
Application:Positive Control; SDS-PAGE; Western Blotting
Research area:Enzyme & Kinase; Infection immunity; Cardiovascular biology
Preparation method:Escherichia coli
| 10µg | $232.00 | |
| 50µg | $580.00 | |
| 200µg | $1,160.00 |
| 1mg | $3,480.00 | |
| 5mg | $8,700.00 |
| 48T | $328.00 | |
| 96T | $468.00 | |
| 96T*5 | $2,106.00 |
| 96T*10 | $3,978.00 | |
| 96T*100 | $32,760.00 |

Antigen:
Matrix Metalloproteinase 8
Synonyms: CLG2; HNC; PMNL-CL; Collagenase 2; Neutrophil Collagenase; PMNL collagenase
Reactivity:Rat
Application:Positive Control; SDS-PAGE; Western Blotting
Research area:Enzyme & Kinase; Infection immunity; Cardiovascular biology
Preparation method:Escherichia coli
| 10µg | $180.00 | |
| 50µg | $450.00 | |
| 200µg | $900.00 |
| 1mg | $2,700.00 | |
| 5mg | $6,750.00 |

Antigen:
Matrix Metalloproteinase 8
Synonyms: CLG2; HNC; PMNL-CL; Collagenase 2; Neutrophil Collagenase; PMNL collagenase
Host:Rabbit
Reactivity:Rat
Application:Western Blotting; Immunohistochemistry; Immunocytochemistry; Immunoprecipitation
Clonality:Polyclonal
Research area:Enzyme & Kinase; Infection immunity; Cardiovascular biology
| 20µl | $103.00 | |
| 100µl | $239.00 | |
| 200µl | $342.00 |
| 1ml | $855.00 | |
| 10ml | $3,420.00 |

Antigen:
Matrix Metalloproteinase 8
Synonyms: CLG2; HNC; PMNL-CL; Collagenase 2; Neutrophil Collagenase; PMNL collagenase
Host:Rabbit
Reactivity:Mouse
Application:Western Blotting; Immunohistochemistry; Immunocytochemistry; Immunoprecipitation
Clonality:Polyclonal
Research area:Enzyme & Kinase; Infection immunity; Cardiovascular biology
| 20µl | $97.00 | |
| 100µl | $227.00 | |
| 200µl | $324.00 |
| 1ml | $810.00 | |
| 10ml | $3,240.00 |
Antigen:
Matrix Metalloproteinase 8
Synonyms: CLG2; HNC; PMNL-CL; Collagenase 2; Neutrophil Collagenase; PMNL collagenase
Host:Mouse
Reactivity:Human
Application:Western Blotting; Immunohistochemistry; Immunocytochemistry; Immunoprecipitation
Clonality:Monoclonal
Research area:Enzyme & Kinase; Infection immunity; Cardiovascular biology
| 20µl | $87.00 | |
| 100µl | $203.00 | |
| 200µl | $290.00 |
| 1ml | $725.00 | |
| 10ml | $2,900.00 |

Antigen:
Matrix Metalloproteinase 8
Synonyms: CLG2; HNC; PMNL-CL; Collagenase 2; Neutrophil Collagenase; PMNL collagenase
Host:293F
Reactivity:Human
Application:Western Blotting; Immunohistochemistry; Immunocytochemistry; Immunofluorescence
Research area:Enzyme & Kinase; Infection immunity; Cardiovascular biology
| 20µl | $79.00 | |
| 100µl | $183.00 | |
| 200µl | $262.00 |
| 1ml | $655.00 | |
| 10ml | $2,620.00 |

Antigen:
Matrix Metalloproteinase 8
Synonyms: CLG2; HNC; PMNL-CL; Collagenase 2; Neutrophil Collagenase; PMNL collagenase
Host:CHO
Reactivity:Human
Application:Western Blotting; Immunohistochemistry; Immunocytochemistry
Research area:Enzyme & Kinase; Infection immunity; Cardiovascular biology
| 20µl | $72.00 | |
| 100µl | $168.00 | |
| 200µl | $240.00 |
| 1ml | $600.00 | |
| 10ml | $2,400.00 |

Antigen:
Matrix Metalloproteinase 8
Synonyms: CLG2; HNC; PMNL-CL; Collagenase 2; Neutrophil Collagenase; PMNL collagenase
Host:Rabbit
Reactivity:Human
Application:Western Blotting; Immunohistochemistry; Immunocytochemistry; Immunoprecipitation
Clonality:Polyclonal
Research area:Enzyme & Kinase; Infection immunity; Cardiovascular biology
| 20µl | $65.00 | |
| 100µl | $153.00 | |
| 200µl | $218.00 |
| 1ml | $545.00 | |
| 10ml | $2,180.00 |













-E90103Gu-000001.png)



-E90103Ra-000001.png)



-SEA103Mu-000001.png)

-RPA103Hu01-000001.png)



-SEA103Hu-000001.png)


-RPA103Ra01-000001.png)